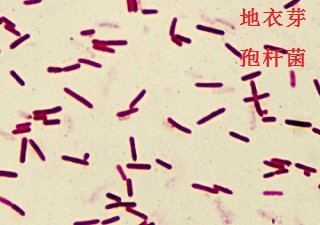
地衣芽孢杆菌

68038-66-4
中文名称
地衣芽孢杆菌
英文名称
BACILLUSLICHENIFORMIS
CAS
68038-66-4
更新日期
2026/06/18 09:34:41
基本信息
中文别名
淡紫紫孢菌地衣芽孢杆菌
地衣芽胞杆菌
地衣芽孢杆菌(BL)
地衣形芽孢杆菌PCR试剂盒
地衣形芽孢杆菌染料法荧光定量PCR试剂盒
地衣形芽孢杆菌探针法荧光定量PCR试剂盒
地衣形芽孢杆菌荧光定量PCR试剂盒(探针法)
英文别名
BACILLUSLICHENIFORMISBacillus lichenformis
Bacillus lichenitormis
Pseudomonas licheniformis
Bacillus licheniformis(Weigmann) Chaester
Bacillus licheniformis (Weigmann) Chester
所属类别
原料药:消化系统用药常见问题列表
概述
芽孢杆菌(Bacillus spp)是一类需氧或兼性厌氧G+(目前也发现有G-),在一定条件下能产生抗逆性内生孢子的化能异养菌。在自然界分布非常广泛,生理特性丰富多样,是土壤和植物微生态优势种群之一。它可产生多种抗生素,包括脂肽类、肽类、磷脂类、多烯类、氨基酸类、核酸类物质,对多种动、植物及人类病原菌起到很好的抑制作用。而且芽孢杆菌还具有很强的蛋白酶、脂肪酶、淀粉酶活性。因此, 芽孢杆菌被广泛应用于医药、农药、食品、饲料加工、环境污染治理等各个行业。 地衣芽孢杆菌(Bacillus licheniformis)是一种革兰氏阳性腐生性微生物,广泛分布于土壤和其它自然环境中,具有耐热、酶系丰富、产酶量更高和安全等诸多优良特性,被认为是较理想的工业生产菌株,其模式菌株的基因组序列也于2004年公布。与枯草芽孢杆菌相比,地衣芽孢杆菌生长温度高5~7℃;其次,其生长速率适中,容易使刚跨膜的未合适折叠得蛋白充分折叠;此外,地衣芽孢杆菌分泌蛋白至培养基中的能力大约是枯草芽孢杆菌的2倍,异源蛋白表达水平已报道达到20~25mg/m ,为所见报道的所有芽孢杆菌表达水平最高者。
地衣芽孢杆菌是芽孢杆菌中较具应用潜力的菌种之一。近年来,国内外对于地衣芽孢杆菌各方面应用的报道日益增多。在医药、饲料加工、农药等行业,取得了较好的研究成果。
地衣芽孢杆菌是一种广泛分布于土壤和其他自然环境的革兰氏阴性菌。地衣芽孢杆菌具有营养要求简单、对不良环境有极强抵抗能力、产酶种类多且产量高、耐热性强、抑制致病菌以及安全无毒等诸多优良特性,因此比较适合用于工业生产,已经被多个国际机构认定为GRAS工业菌株。地衣芽孢杆菌应用范围较广,能有效预防水产动物肠炎,分解水中有毒有害物质,能促进饲料中营养素降解,能调整肠道菌群失调,减少肠道细菌感染,能产生抗性物质从而抑制致病菌生长繁殖,能作为益生菌调节动物的肠道功能,增强动物的机体免疫能力,减少饲养动物的发病率,还能作为生物农药防治植物病害,改善农作物的品质因此地衣芽孢杆菌在水产业、畜牧业、林业、食品工业和医药行业均有广泛的应用。
同时地衣芽孢杆菌是产生一种具有重要工业生产价值的耐高温α-淀粉酶(thermostable α-amylase)的优良菌株,能分解淀粉(天然底物通常是α-1,4糖苷键),产物为糊精、低聚糖和单糖类。它是最早实现了工业化生产并且迄今为止用途最广、产量最大的一个酶制剂品种,几乎占整个酶制剂总产量的50% 以上。近年来,地衣芽孢杆菌由于其安全性、产酶丰富以及能抑制致病细菌的特性在食品工业上的应用也越来越多。
图1为地衣芽孢杆菌
产品描述
地衣芽孢杆菌自身能够合成α-淀粉酶、蛋白酶、脂肪酶、纤维素酶等,在消化道中与动物体内的消化酶类一同发挥作用。 地衣芽孢杆菌是好氧菌,能迅速消耗环境中的游离氧,造成肠道低氧,促进有益厌氧菌生长,并产生乳酸等有机酸类,降低肠道pH值,间接抑制其它致病菌生长。作用机制
1、地衣芽孢杆菌自身能够合成α-淀粉酶、蛋白酶、脂肪酶、纤维素酶等,在消化道中与动物体内的消化酶类一同发挥作用。
2、地衣芽孢杆菌是好氧菌,能迅速消耗环境中的游离氧,造成肠道低氧,促进有益厌氧菌生长,并产生乳酸等有机酸类,降低肠道pH值,间接抑制其它致病菌生长。
3、刺激动物免疫器官的生长发育,提高机体免疫力。
生物学特性
地衣芽孢杆菌是一种在土壤中常见的革兰氏阳性嗜热细菌,其最适合生长温度为30 ℃,但酶的最适合分泌温度为37 ℃,地衣芽孢杆菌还能产生许多具有热温度性较强的蛋白酶,而且抵抗恶劣环境的能力比较强。地衣芽孢杆菌与解淀粉芽孢杆菌的亲缘关系最近,两者DNA同源性在9%~15%。地衣芽孢杆菌培养菌落呈圆形,表面不光滑。镜检菌株为直杆状,两端呈圆形,芽孢有运动能力。能利用丙酸盐是地衣芽孢杆菌才具有的生化特征,地衣芽孢杆菌还具有淀粉水解、利用柠檬酸盐、明胶液化、硝酸盐还原以及精氨酸脱水酶生产能力。根据以上生理生化特征结合16Sr DNA序列可以对地衣芽孢杆菌进行鉴定。
药理作用
本品为地衣芽孢杆菌活菌制剂,主要作用机理是以菌治菌。服用本品后,地衣芽孢杆菌在肠道内迅速生长繁殖,造成肠道低氧环境。对肠道内的双歧杆菌、乳酸杆菌、拟杆菌、消化链球菌等有益健康的厌氧菌的生长繁殖有促进作用,对葡萄球菌、白色念珠菌、酵母样菌等致病菌则有拮抗作用,通过这种双重作用可以调整肠道菌群失调,维持人体肠道微生态平衡,从而对肠道疾病达到治疗和预防的目的。应用于医药研究
与传统的化学药物、抗生素、中药相比较, 其作用机制完全不同。整肠生主要是通过以菌治菌的方法[17] , 地衣芽孢杆菌口服以后以活菌形式进入肠道内, 在生长代谢中能产生多种抗菌活性物质, 如短杆菌肽、枯草杆菌素、制霉菌素和头孢菌素C 等, 可抑制肠道中的致病菌。而其是兼性厌氧菌, 具有生物夺氧的作用, 可促进益生菌生长而使肠道中微生态环境达到平衡, 使腹泻等症状缓解或消失。地衣芽孢杆菌尚有促进巨嗜细胞非特异性吞噬作用, 由于该菌不是肠道固有细菌, 不会在肠道中长期定植, 一般在停药后10 d 即全部排出体外, 仅起治疗作用而不会造成远期不良反应。
作用机制
1.生物夺氧 地衣芽孢杆菌为需氧菌,在生长过程中消耗大量的氧气, 使得肠道内氧气浓度降低,为肠道内的生理性厌氧菌,如双歧杆菌、乳酸杆菌、消化链球菌、类杆菌等菌的生长繁殖创造有利条件。同时使得需氧的有害病原菌(如大肠杆菌) 的生长由于缺氧受到抑制。通过支持生理性厌氧菌的增殖,抑制致病菌的生长,使菌群失调得以调整,使肠道功能得以恢复,最终使胃肠道的微生态体系处在健康平衡的状态, 动物的免疫力得到提高。2.生物拮抗体 外试验表明,地农芽孢杆菌对葡萄球菌、白色念珠菌有很强的拮抗作用。地衣芽孢杆菌在生长代谢过程能产生多种抗菌物质,如短杆菌肽、枯草菌素、多粘菌素、制霉菌素和头孢菌素C 等。因此,其对常见的致病性大肠杆菌、沙门氏菌和金黄色葡萄球菌均有较强的抑制作用。
3.产生多种酶类和营养物质 地衣芽孢杆菌在生长过程中,可分泌蛋白酶、淀粉酶和脂肪酶等多种有助于消化吸收的酶类,此外,在降低和消除抗营养因子上也发挥了重要作用。地衣芽孢杆菌DSM13 含有高度保守的蛋白分泌系统,没有聚酮体合成体系,但能形成脂肽性地衣素。已经确定的胞外酶有淀粉酶、β-半乳糖苷酶、纤维素酶、几丁质酶、果聚糖酶、麦芽糖淀粉酶、多聚糖降解酶、碱性蛋白酶、锌蛋白酶等。目前,已经从地衣芽孢杆菌不同菌株中克隆出的有关重要酶编码基因有:青霉素酶、α-淀粉酶、果胶裂解酶、多酚氧化酶、γ-谷氨酰转肽酶、β-1,3-1,4-葡聚糖酶、蛋白酶、纤维素酶、β-半乳糖苷酶、碱性磷酸酶等编码基因。这些酶具有降解饲料中复杂碳水化合物,如果胶、葡聚糖、纤维素等。
地衣芽孢杆菌在一定条件下能产生抗逆性内生孢子,可以产生脂肽类、肽类、磷脂类、多烯类和氨基酸类等多种抗生素, 对多种病原菌起到很好的抑制作用。地衣芽孢杆菌同时能产生多种营养物质,如维生素、氨基酸、有机酸、促生长因子等,参与动物机体新陈代谢, 为机体提供营养物质。
4.增强机体免疫功能 地衣芽孢杆菌生长条件要求低,繁殖快,能迅速定植在肠黏膜上,在短时间内成为肠道的优势菌群。能调节动物肠道菌群平衡,改善肠道微生态环境,促进动物生长、减少动物肠道疾病的发生,提高动物机体的抗病力;同时其还具有免疫抑制、竞争性吸附及合成抑菌物质等多方面的作用。地衣芽孢杆菌能刺激动物免疫器官的生长发育,激活淋巴细胞,提高免疫球蛋白和抗体水平,增强细胞免疫和体液免疫功能,提高机体免疫力。有试验发现,仔兔饲喂地衣芽孢杆菌20 d 及40 d 后, 其免疫器官生长发育较对照组迅速,成熟快,并且胸腺、脾脏重量等显著提高。地衣芽孢杆菌的免疫促进作用的机理是:口服芽孢杆菌后,其作用于肠道集合淋巴结的抗原结合位点或通过调整动物的微生物菌群,尤其是增加双歧杆菌菌群数量,从而间接地发挥免疫赋活的作用, 提高机体的局部或整体防御功能,从而达到抗应激、防病和抗病的作用。
制备方法
一种高芽孢率地衣芽孢杆菌的生产方法,包括以下步骤: 1) 摇瓶培养:将地衣芽孢杆菌接种到摇瓶培养基上,接种量为体积比1:(80~120),进行摇床培养;
2) 种子罐培养:将步骤1)得到的地衣芽孢杆菌菌液接种到种子培养基上,接种量体积比1:(80~120),进行培养;
3) 发酵罐培养:将步骤2)得到的地衣芽孢杆菌菌液接种到发酵基础培养基上,接种量体积比1:(80~120),进行发酵培养,发酵温度35~37℃,转速为180~200rpm/min,通气量为1:(0.7~1.0),发酵过程pH值为6.0~7.8;整体发酵时间为30~36h;
发酵基础培养基配方为:玉米淀粉2~4%;豆粕1~3%;蛋白胨0.5~1.5%;硫酸镁0.04~0.06%;碳酸钙0.5~0.7%;磷酸二氢钾0.2~0.4%;消泡剂0.015~0.025%;
4) 发酵23~25h补入发酵体积的0.03~0.04%灭菌氯化锰溶液。
有关地衣芽孢杆菌的概述、生物学特征、制备方法、应用等是由Chemicalbook的旭艳编辑整理。(20160-04-18)
适应症
1.用于细菌与真菌引起的急慢性腹泻。
2.用于肠道菌群失调症。
3.用于急慢性肠炎。药物相互作用
本品活菌对三代头孢菌素、庆大霉素、氧哌嗪青霉素等药不敏感。对环丙沙星、泰能等药高度敏感,故服用本品时应停用此类抗菌药物。应用
1.地衣芽孢杆菌应用于植物病害防治地衣芽孢杆菌能产生多种抗菌物质,对一些植物病原菌有较好的抑制作用。因此,将其抗菌物质开发为生物农药,成为研究的热点。从20世纪80年代开始,将地衣芽孢杆菌应用于植物病害防治的研究已经起步。地衣芽孢杆菌所产生的抗菌物质主要是一些蛋白类抗菌物质(几丁质酶、抗菌蛋白、多肽类)。国外还有报道指出,地衣芽孢杆菌可产生苯乙酸一类的抗菌物质。抗菌物质抑制植物病原菌的途径有:作用于病原菌的细胞壁、细胞膜;与膜相关的受体蛋白相互作用;作用于能量代谢系统;提高植物的抗病力。
2.地衣芽孢杆菌应用于饲料加工
根据我国农业部公布的结果,允许饲用的芽孢杆菌菌种有枯草芽孢杆菌(Bacillus subtilis)、纳豆芽孢杆菌(Bacillus natto)、蜡样芽孢杆菌(Bacilluscereus)、凝结芽孢杆菌(Bacillus coagulans)、缓慢芽孢杆菌(Bacillus lentus)、地衣芽孢杆菌、短小芽孢杆菌(Bacillus pumilus)等12种。芽孢杆菌在制剂中以内生孢子形式存在。孢子进入动物肠道后, 在肠道上部能迅速复活并分泌活性很强的蛋白酶、脂肪酶、淀粉酶, 有助于降解植物性饲料中某些复杂的碳水化合物, 产生具有拮抗肠道致病菌的多种物质;同时通过生物夺氧消耗肠道内的氧气造成厌氧环境, 肠道原籍优势菌大多属厌氧菌, 而有害菌和外来菌多为需氧菌, 从而有利于维持肠道生态平衡。
3.地衣芽孢杆菌应用于环境污染防治
1)降解拟除虫菊酯类农药残留:在拟除虫菊酯类农药残留降解菌筛选试验中,筛选出地衣芽孢杆菌qw5所产生的特异性酶可与氰戊菊酯羧酸酯键断裂的相应产物发生作用,加速其分解。
2)对于重金属的吸附:采用地衣芽孢杆菌死菌体吸附水中的Cr6+,其研究结果与报道的同类研究相比较。地衣芽孢杆菌死菌体对Cr6+具有更好的吸附效果, 在优化条件下,即温度为50℃,摇床转速140r·min-1,溶液pH值2.5, 吸附时间2h,菌体浓度1g·L-1,Cr6+起始浓度300mg·L-1,菌体对Cr6+有最大吸附量60.5mg·g-1。
4.地衣芽孢杆菌在食品中的应用
1)酿造业:地衣芽孢杆菌由于其丰富的产酶能力和良好的环境适应能力而被应用于酿造工业,被认为是酱香型白酒高温大曲中特有的微生物。刘桂君等从牛栏山酒厂生产用大曲中分离纯化得到地衣芽孢杆菌,用所得液体菌株做种子制备麸曲添加到酒醅中,所得地衣芽孢杆菌基酒比普通基酒乙酸乙酯含量提高,酒体协调、自然,说明地衣芽孢杆菌的添加能提高牛栏山二锅头基酒的质量。
2)食品加工:地衣芽孢杆菌产生的蛋白酶具有较强的水解能力,因此在动物食品加工及水解大豆产多肽方面应用广泛。大豆是一种优质高蛋白脂肪作物,可制成各类食品,豆粕是大豆提取油后的副产品。其中丰富的蛋白可以采用地衣芽孢杆菌蛋白酶加以利用,制成肽类饮料。乐超银等[9]从土壤中分分离得到高产蛋白酶的地衣芽孢杆菌,用该地衣芽孢杆菌以大豆分离蛋白为原料进行发酵生产,通过对发酵条件进行优化,大豆多肽得率达到70%,其中大豆蛋白多肽含量可达19.2 mg/mL,而且所得大豆多肽发酵液具有良好的口感,可作为食品原料,具有较高的营养价值养殖业:由于地衣芽孢杆菌对致病菌有一定的抑制作用,而且地衣芽孢杆菌所产生的丰富的蛋白酶能促进肠道消化,因此地衣芽孢杆菌在饲料添加剂方面有较广泛的应用。将主要成分为地衣芽孢杆菌的芽孢杆菌制剂添加到蛋鸡饲料中,发现饲料的转化率得到提高,蛋鸡的发病率明显减少,而且鸡蛋的蛋壳硬度相比对照组增加2.55%,产蛋率有所提高并且破蛋率降低,同时还能改善蛋黄颜色。
3)地衣芽孢杆菌在水产养殖方面也有一定的应用价值。丁贤等发现用含有地衣芽孢杆菌的饲料投喂南美白对虾,结果发现对虾体内脂肪酶、淀粉酶以及蛋白酶的含量均明显高于未喂地衣芽孢杆菌的对虾,且地衣芽孢杆菌组对虾的发病率较低,体重及产量明显高于未喂地衣芽孢杆菌组。
5.地衣芽抱杆菌对作物生长的作用
地衣芽孢杆菌能产生多种活性物质,刺激作物生长。神州汉邦北京生物技术有限公司公布了一项关于地衣芽抱杆菌产玉米素、异戊烯基腺嘌呤和玉米素核苷植物生长调节剂的专利。该发明提供了用于产生玉米素、异戊烯基腺嘌呤和玉米 素核苷的地衣芽孢杆菌、含有该地衣芽孢杆菌及其代谢产物的植物生长调节剂,以及该植 生长调节剂的生产和使用方法。